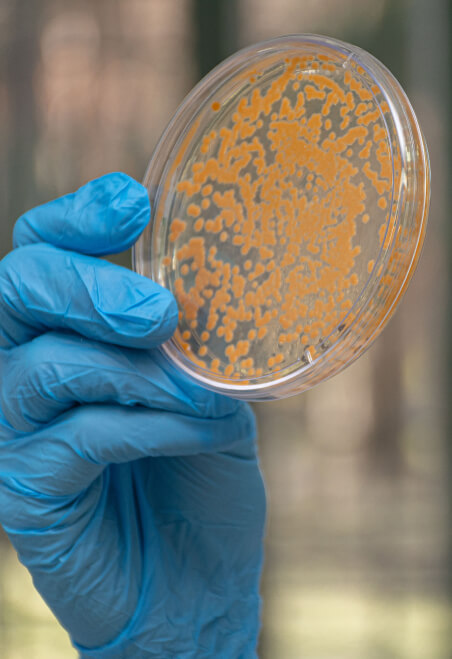

¿Qué son
los extremófilos?

Seres vivos capaces de desarrollarse en
condiciones extremas, donde la mayoría
de las formas de vida no podrían sobrevivir.
La tierra primitiva hace 3500 millones de años donde se
inició la vida sin O2, con elevada radiación UV, aguas
salinas alcalinas y cargadas de arsénico, fue uno de los
ambientes más extremos conocidos. Los sobrevivientes de
estas condiciones fueron microorganismos extremófilos
capaces de crecer sin nutrientes, en condiciones de
sequía, y cambios drásticos de temperatura, alta
salinidad y radiación UV.

Plataforma
de investigación
PunaBio

Los extremófilos en la puna
El secreto de PunaBio
La Puna, como se la conoce en Argentina, es un desierto
de altura (más de 3500 m sobre el nivel del mar) que
abarca Chile (Atacama) Bolivia y Perú (Altiplano). Está
plagada de salares, volcanes activos, humedales salinos
y suelos desérticos.

Es considerado de los lugares más extremos para la vida en el
planeta y reproduce las condiciones de la tierra primitiva donde
habitaban las primeras formas de vida: los extremófilos.
También se recrean condiciones de ambientes
extraterrestres de ambientes hipersalinos fríos,
sin oxígeno, como los que existen hoy en el
planeta Marte. Esto los convierte en laboratorios
ambientales emblemáticos para estudios de
astrobiología y del origen de la vida.


En los últimos años tomó relevancia el hallazgo
de ecosistemas microbianos extremófilos tipo
estromatolitos en la Puna Argentina, reportado
en 2009 por la investigadora del CONICET y
directora de PunaBio, Dra. María Eugenia Farías.
Durante la última década, la reconocida bióloga y su equipo
de científicos trabajaron en la recolección, aislamiento,
caracterización y selección de estos microorganismos
puneños extremófilos, logrando una colección única.

El estudio genético de las bacterias de esos
ambientes ha llevado a entender los genes
que desencadenan los procesos por los
que logran sobrevivir a las situaciones de
estrés ambiental, y cómo trasladar esas
propiedades a los cultivos.

Descubrí cómo
aplicamos los extremófilos
a nuestros productos
Estromatolitos:
Los inventores
de la fotosíntesis
Los estromatolitos son los fósiles más antiguos
del planeta, lo habitaron y dominaron hace 3500
millones de años, en los mares primitivos donde
abundaba el ambiente hipersalino, el Arsénico y
la falta de oxígeno.
Estos ecosistemas microbianos inventaron la
fotosíntesis, liberaron oxígeno, captaron carbono
del ambiente y los transformaron en materia
orgánica o mineral (Carbonato de calcio).
Les llevó millones de años, pero
oxigenaron primero los mares,
luego la atmósfera y finalmente
crearon la capa de Ozono,
preparando al planeta para la
evolución de nuevas formas de
vida como plantas y animales.


